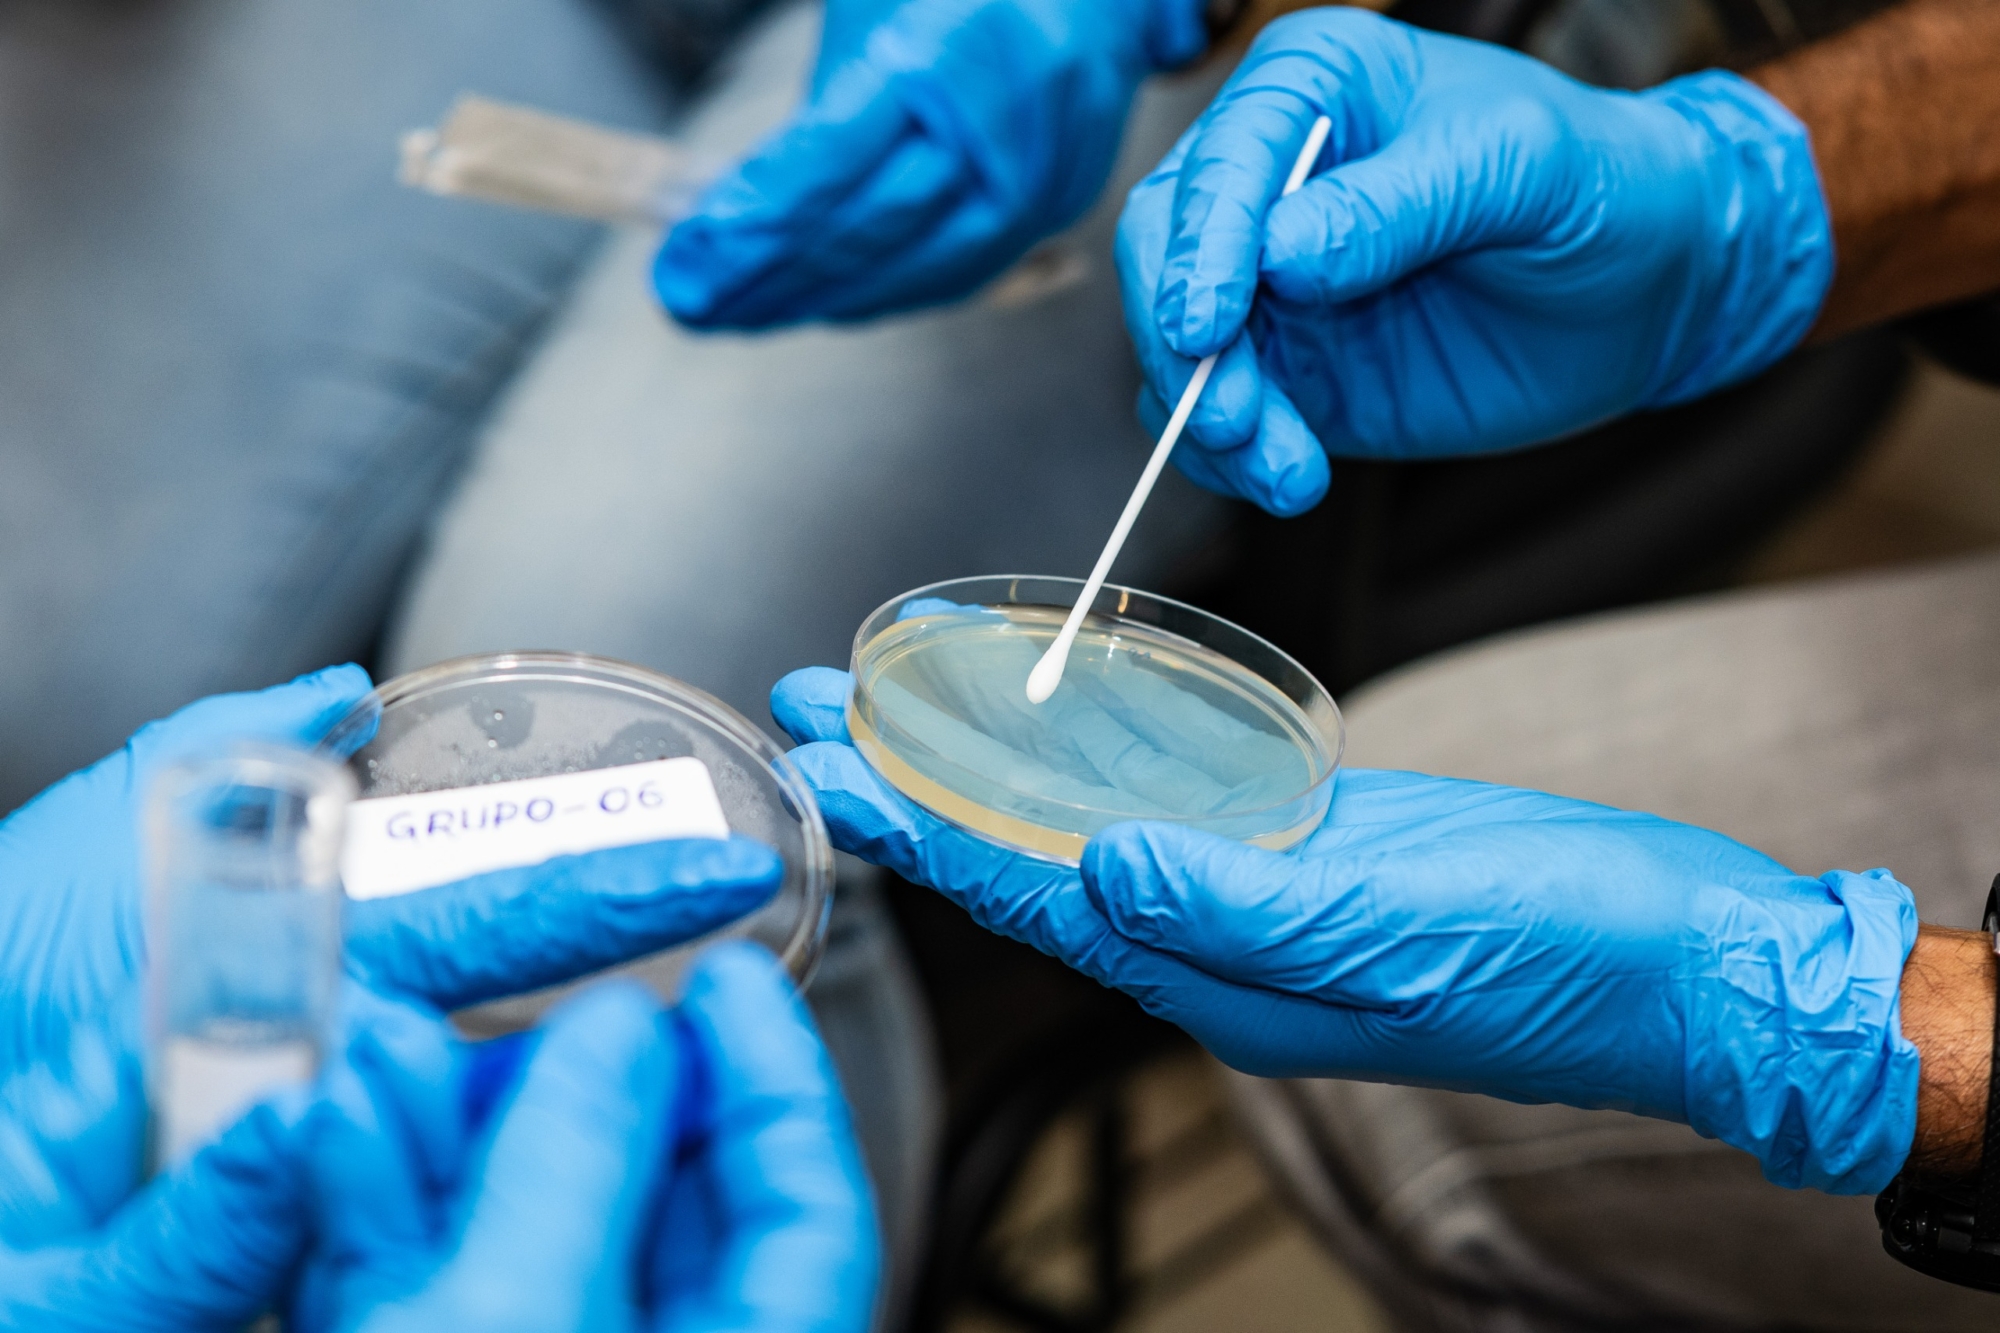

Fiocruz Amazônia capacitará 4.500 agentes de saúde em educação e saúde ambiental na capital e interior do Amazonas com apoio da Johnson & Johnson Foundation
Com a finalidade de qualificar 4.500 profissionais vinculados aos sistemas de saúde dos municípios do Amazonas, visando combater a desinformação acerca dos processos de adoecimento e reforçar a importância dos cuidados com a qualidade da água e a consciência sanitária na região amazônica para a redução da ocorrência de doenças, a Fiocruz Amazônia e a Johnson & Johnson, por meio da plataforma global de impacto social J&J CareCommunity, lançaram na sexta-feira, 30/01, o Projeto Educa Saúde Ambiental: formação continuada em saúde e ambiente na Amazônia. O curso oferecido tem carga horária de 20 horas e visa a formação de agentes comunitários de saúde, agentes de combate a endemias e agentes de saúde indígena, no monitoramento da qualidade da água utilizada em comunidades rurais ribeirinhas, localizadas em áreas remotas do Estado. O lançamento contou com a participação de representantes de instituições parceiras na execução do projeto, Escritório de Captação de Recursos da Fiocruz e Gerência de Comunicação Corporativa e Responsabilidade Social da Johnson & Johnson Foundation.

O projeto conta com a parceria do Conselho de Secretarias Municipais de Saúde do Amazonas (Cosems-AM), Fundação de Vigilância em Saúde Dra Rosemary Costa Pinto (FVS-RCP), Escola de Saúde Pública da Secretaria Municipal de Saúde (Semsa-Manaus). O curso, ao todo, já capacitou 140 agentes de saúde dos municípios do Careiro Castanho, Manacapuru e Manaus. Estruturado em cinco módulos, o curso é presencial, está sendo proposto para ter no máximo 30 participantes por turma de agentes e vai abranger, inicialmente, 22 municípios do Amazonas. São eles: Autazes, Atalaia do Norte, Benjamim Constant, Borba, Careiro Castanho, Careiro da Várzea, Coari, Humaitá, Iranduba, Itacoatiara, Lábrea, Manacapuru, Manaus, Manicoré, Maués, Nova Olinda do Norte, Parintins, Rio Preto da Eva, Santo Antonio do Içá, São Paulo de Olivença, Tabatinga, Tefé. O material didático utilizado foi produzido exclusivamente para o projeto, levando em consideração a vivência dos agentes nos seus territórios.
“São textos, dinâmicas, atividades práticas, exibição de vídeos, sempre valorizando o conhecimento e os saberes dos agentes”, explicou a coordenadora geral do projeto, Ani Beatriz Matsuura, que é pesquisadora em Saúde Pública da Fiocruz Amazônia. O evento de lançamento contou com a entrega simbólica de certificados aos Agentes de Combate a Endemias (ACEs), que participaram da formação. Representando a turma de Manacapuru, a enfermeira Flaviane Gomes, coordenadora da Atenção Básica do município, recebeu o documento e destacou a importância da formação para os ACS. “Conseguimos capacitar mais de 100 Agentes Comunitários de Saúde que atuam na zona rural do município com o curso da Fiocruz, que é de extrema importância para quem se encontra em localidades remotas, onde muitas das vezes a população não tem água potável e a única informação sobre os cuidados a serem tomados com a água é dada através dos ACS”, afirmou.

O risco de ingestão de água contaminada, segundo a enfermeira, aumenta no atual período de cheias dos rios. Situada na bacia do Solimões, Manacapuru possui inúmeras comunidades que sofrem com o isolamento na época da vazante e dependem unicamente da água do afluente para abastecer suas casas. “Estamos entrando justamente no período das cheias e a atuação dos ACS vai conseguir conscientizar e informar a população nesse momento sobre o uso correto da água, garantindo que ela esteja saudável para consumo”, observou Flaviane, destacando a relevância da parceria da Fiocruz com o município de Manacapuru ao abrir um leque de oportunidades de capacitação.

O fiscal sanitário Renato Limpa Ramos, da FVSRCP, falou em nome dos ACE que participaram da formação em Manaus. “Gostaria de expressar nosso mais profundo agradecimento pela semana de aprendizado. Foi, acima de tudo, um encontro entre conhecimento, território e compromisso com a Amazônia. Esse curso nos mostrou que qualidade da água não é apenas um parâmetro técnico, é dignidade, saúde, justiça ambiental e cuidado com quem vive nas margens dos rios e com quem vive no trabalho cotidiano da vigilância e da proteção da vida”, falou, emocionado, agradecendo a condução do processo formativo sob coordenação da Fiocruz e aos gestores que acreditam na capacitação como um investimento futuro.

A pesquisadora Ani Matsuura destacou o pioneirismo do Educa Saúde Ambiental enquanto projeto de formação continuada em saúde e ambiente voltada para os agentes de saúde na região amazônica. “Temos poucos cursos com essa temática e essa iniciativa se reveste de maior relevância diante do que está acontecendo na Amazônia, com impacto direto na saúde da população ribeirinha, cuja vida gira em torno da água, afetando em todos os aspectos, inclusive da alimentação. Sabemos que os agentes são os principais mediadores e reguladores do acesso ao serviço de saúde nesse contexto amazônico, pois formam uma grande rede de apoio para populações ribeirinhas e de áreas urbanas periféricas”, afirmou a coordenadora geral do projeto.

Matsuura enfatizou que os ACS são vitais para o acesso à saúde nessas localidades. “Por esta razão, o projeto propõe um treinamento interdisciplinar para melhorar a compreensão da conexão entre questões ambientais e de saúde, com o objetivo de qualificar melhor o agente de saúde a compreender os mecanismos que interrelacionam problemas ambientais aos problemas de saúde e como podem ser mitigados por meio da educação a partir de conhecimentos e saberes compartilhados”, explicou, durante apresentação do projeto. Segundo ela, o Educa Saúde Ambiental espera potencializar o papel dos agentes de saúde como mediadores entre o conhecimento científico e o tradicional, melhorando a saúde e a qualidade de vida das comunidades em meio aos desafios das mudanças climáticas.

Manaus, Manacapuru e Careiro Castanho foram os primeiros municípios a receberem as equipes de facilitadores do projeto. As próximas turmas acontecerão em Borba, Autazes, Tabatinga e Presidente Figueiredo, em fevereiro e março. O projeto tem prazo de duração de 12 meses. Os módulos estão divididos em “Água e sociedade amazônica”, “Qualidade da água e monitoramento de microrganismos”, “Doenças veiculadas pela água, ambiente e prevenção”, “Saneamento, higiene e controle de microrganismos” e “Ações Integradas em Saúde Única”, trabalhando temáticas como acesso a água e o papel das mulheres, escassez da água, qualidade da água e a detecção de microrganismos, esgoto e leptospirose, hepatite A, diarreias infecciosas e parasitoses, infecções fúngicas, contaminação química dos rios e a água para consumo, higienização das mãos, desinfetantes e o controle de microrganismos.

DIÁLOGO COM O TERRITÓRIO AMAZÔNICO
O Projeto Educa Saúde Ambiental nasce com a proposta de reforçar a importância do diálogo, da cooperação e do compromisso com o Sistema Único de Saúde e o território amazônico. “Trata-se de uma ação construída de forma colaborativa, que nasce da escuta das realidades locais e da necessidade de fortalecer o Sistema Único de Saúde nos contextos mais remotos do nosso estado”, ressalta a diretora da Fiocruz Amazônia, Stefanie Lopes, reconhecendo a importância das parcerias público-privadas para a execução das atividades propostas. “Destaco a interação e a importância do Escritório de Captação de Recursos da Fiocruz nesse diálogo com pessoas e cenários diferentes, mas que precisam convergir, em direção a uma sociedade mais justa e onde todos tenham bem-viver”, afirmou, destacando que na Amazônia, a relação entre saúde, ambiente e território é indissociável. “A qualidade da água é elemento central para prevenção de doenças e para a promoção da vida. Mais do que um curso, esse projeto representa o investimento em pessoas que estão na linha de frente do cuidado, que conhecem o território, as comunidades e seus desafios, é acima de tudo, uma aposta na educação como ferramenta de transformação social e na saúde como direito”, reforçou.

Presente ao lançamento, Bruno Barbosa Muniz, da área de Cooperação Internacional do Escritório de Captação de Recursos, observa que a parceria com a Johnson & Johnson Foundation demonstra como o diálogo qualificado com o setor privado pode viabilizar iniciativas estruturantes, com escala, foco territorial e impacto direto na vida das populações amazônicas. “Nosso papel é criar essas pontes, garantindo alinhamento institucional, transparência, rigor técnico e sustentabilidade das ações, para que projetos como o Educa Saúde Ambiental cheguem aos territórios onde são mais necessários e fortaleçam de forma concreta a atuação dos agentes de saúde e do SUS na Amazônia”, enfatizou.
ILMD/Fiocruz Amazônia, Por Júlio Pedrosa
Fotos: Michell Mello / Especial para o ILMD/ Fiocruz Amazônia e Júlio Pedrosa



